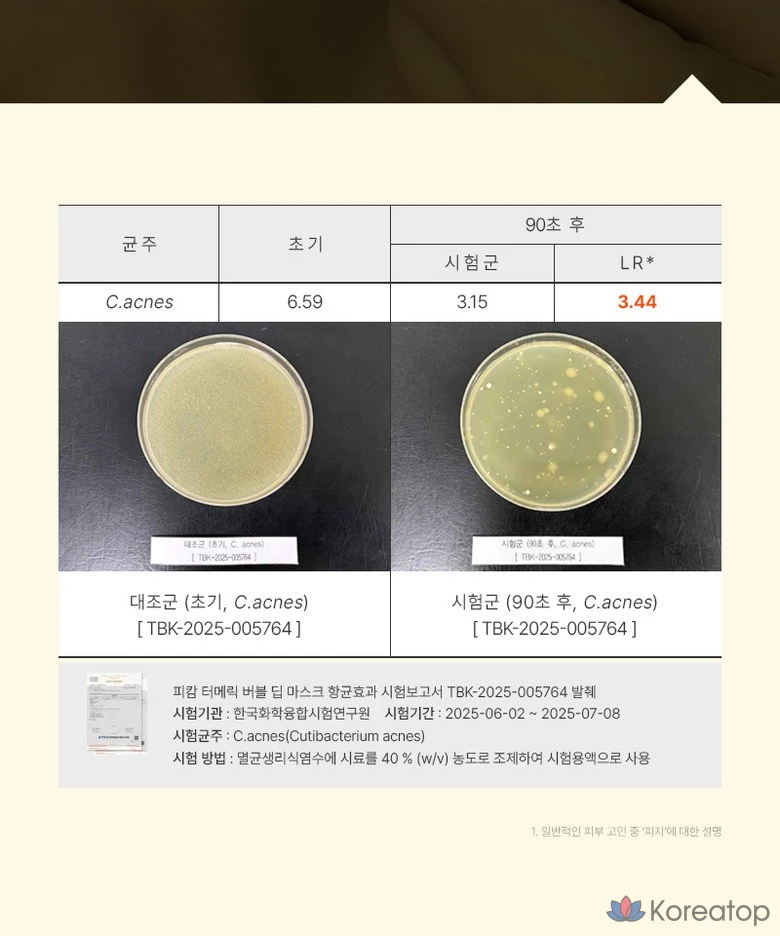

Тканевая маска для лица P.CALM Turmeric Curcumin Bubble Deep Mask, 1 шт.
Вам также может понравиться
Очищающая глиняно-пузырьковая маска (смываемая)
Для всех типов кожи, особенно для комбинированной, жирной, проблемной и чувствительной
Экстракт корня куркумы, салициловая кислота (BHA), лимонная кислота (AHA), глина (каолин, иллит, бентонит), газированная вода
Глубокое очищение пор, себорегуляция, успокаивающее действие, уменьшение покраснений, мягкое отшелушивание
Превратите рутинный уход в настоящее SPA-приключение с кислородной маской P.CALM! Её уникальная текстура золотистой глины при контакте с кожей трансформируется в облако нежных пузырьков, которые проникают глубоко в поры. Механика проста: вы наносите гладкую массу, а через 3-5 минут она начинает активно пениться, выталкивая загрязнения, излишки себума и ороговевшие клетки. Формула на основе экстракта куркумы и BHA-кислоты (салициловой) эффективно успокаивает покраснения, борется с несовершенствами и выравнивает тон, не пересушивая кожу. После умывания кожа становится идеально чистой, гладкой, матовой и ощутимо более спокойной.














 Telegram
Telegram Вконтакте
Вконтакте Max
Max